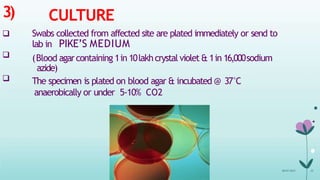
3)


CULTURE
 Swabs collected from affected site are plated immediately or send to
lab in PIKE’S MEDIUM
(Blood agarcontaining 1in 10lakhcrystal violet & 1in 16,000sodium
azide)
The specimen is plated on blood agar & incubated @ 37°C
anaerobically or under 5-10% CO2
08-07-2015 33

1) Streptococcus pyogenes is a gram positive bacterium that can cause a variety of infections in humans.
2) It is classified based on its hemolytic properties when cultured on blood agar as alpha, beta, or gamma hemolytic. S. pyogenes causes beta hemolysis.
3) S. pyogenes produces several toxins and enzymes that contribute to its virulence, allowing it to cause infections in the respiratory tract, skin, and other tissues. Common infections include pharyngitis, impetigo, cellulitis, and necrotizing fasciitis.